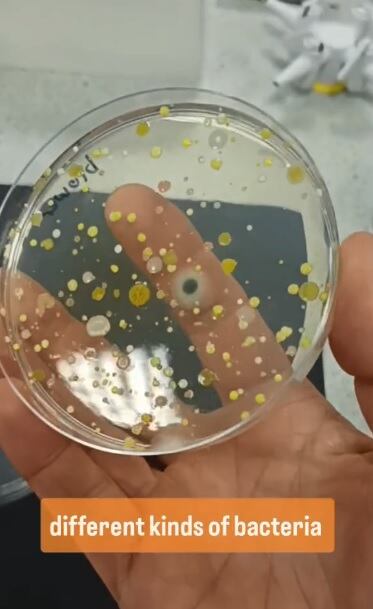
La placa que estuvo cerca del secador se llenó rápidamente de una variedad de bacterias y hongos. (Foto: @devonscience)

¿Te has preguntado si las máquinas para secarte las manos en los baños públicos son realmente higiénicas? Un experimento que se ha vuelto viral en TikTok expone una realidad que puede ser bastante alarmante.
La científica estadounidense Devon Science (@devonscience) llevó a cabo una prueba bastante sencilla, pero que dio resultados muy reveladores: colocó una placa de Petri, un recipiente utilizado para cultivar bacterias, debajo de un secador de manos en un baño público. Luego, hizo lo mismo con otra placa en su laboratorio, exponiéndola al aire del ambiente.
Los resultados fueron impactantes. La placa que estuvo cerca del secador se llenó rápidamente de una variedad de bacterias y hongos, visibles como manchas de colores. Por otra parte, la placa del laboratorio permaneció prácticamente limpia.
La experta admitió que es por eso que evita usar secadores de manos y, en su lugar, opta por usar toallas de papel o simplemente sacudirse las manos.
¿Cómo es posible que los secadores de manos estén tan contaminados? La respuesta es sencilla: aspiran el aire del baño, que está lleno de microorganismos provenientes de los inodoros, lavabos y otras superficies.
Al soplar este aire contaminado sobre nuestras manos, los secadores dispersan las bacterias por todas partes.
Aunque Devon no reveló qué bacterias fueron las que identificó, investigaciones anteriores encontraron una amplia variedad de microorganismos en estos dispositivos, incluyendo E. coli, hepatitis y otras bacterias fecales.
Algunos estudios sugieren que instalar filtros HEPA en los secadores de manos podría ayudar a reducir significativamente la cantidad de bacterias dispersadas; sin embargo, la solución más simple y efectiva sigue siendo utilizar toallas de papel o sacudirse las manos al aire libre.
¿Cómo evitar enfermedades al utilizar un baño público?
Los baños públicos son lugares con una alta concentración de bacterias. Para minimizar el riesgo de contraer alguna enfermedad, el medio Diario de Sevilla compartió las siguientes recomendaciones:
Evita tocar superficies innecesarias, como picaportes, grifos o dispensadores de jabón, con las manos desnudas. Utiliza papel higiénico o una toalla desechable para manipular estos objetos. Además, al sentarte en el inodoro, intenta mantener una pequeña distancia entre tu cuerpo y el asiento.

Después de usar el baño, lávate las manos con agua tibia y jabón durante al menos 20 segundos, prestando especial atención al área entre los dedos y debajo de las uñas. Si no tienes acceso a agua y jabón, utiliza un desinfectante de manos con al menos un 60% de alcohol. Evita secarte las manos con secadores de aire, ya que estos pueden contener una gran cantidad de bacterias.
Por otra parte, evita caminar descalzo en estos sitios, evita tocarte el rostro con las manos sin lavar y no olvides educar a los niños para que sigan estas medidas de higiene.











